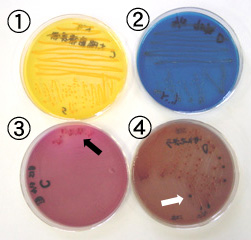

살모넬라
"오늘의AI위키"의 AI를 통해 더욱 풍부하고 폭넓은 지식 경험을 누리세요.
1. 개요
살모넬라는 장내세균과에 속하는 세균으로, 1880년 카를 요제프 에베르트에 의해 처음 기록되었으며, 현재는 두 종(S. bongori, S. enterica)과 6개의 아종으로 분류된다. 살모넬라는 식중독, 장티푸스, 파라티푸스열 등의 질병을 유발하며, 오염된 음식 섭취를 통해 감염된다. 살모넬라균은 다양한 숙주 세포를 감염시키며, 세포 내 기생성을 갖는다. 예방을 위해서는 식품을 충분히 가열하고, 위생적인 환경을 유지하는 것이 중요하다. 장티푸스 백신 접종도 감염 예방에 도움이 된다.
더 읽어볼만한 페이지
- 살모넬라 - 코코리츨리 유행
코코리츨리 유행은 1545년부터 1813년까지 아스텍 제국과 멕시코에서 발생한 치명적인 전염병으로, 수백만 명의 사망자를 발생시켜 아스텍 사회에 큰 피해를 입혔으며, 다양한 요인이 복합적으로 작용하여 멕시코 남부와 중부 고지대를 중심으로 확산되었다. - 대농무기 - 구제역
구제역은 전염력이 매우 강한 가축 질병으로, 구제역 바이러스에 의해 발생하며 고열, 입과 발굽의 수포, 과다한 타액 분비 등의 증상을 보이고, 다양한 혈청형이 존재하며 여러 경로로 전파되어 진단 시 RT-PCR, ELISA 검사가 필요하고 살처분 등의 강력한 방역 조치가 시행된다. - 대농무기 - 제초제
제초제는 농업 생산성 향상 및 도시 환경 관리를 위해 잡초를 제거하는 데 사용되는 물질이며, 화학 구조, 작용 방식 등에 따라 분류되고, 환경 오염 및 인체 유해성 등의 문제점을 가지고 있다. - 감마프로테오박테리아 - 레지오넬라
레지오넬라는 냉각탑 등 인공 수계 환경에서 증식하여 에어로졸 형태로 사람에게 흡입되어 폐렴인 레지오넬라증과 폰티악열을 유발하는 세균이며, 항생제로 치료하고 급수 시스템 개선 및 증식 조절을 통해 예방한다. - 감마프로테오박테리아 - 장염비브리오균
장염비브리오균은 해수와 해산물에 서식하며 오염된 해산물 섭취 시 식중독을 일으키는 호염성 세균으로, 설사, 복통, 구토 등의 증상을 유발하며 해산물을 익혀 섭취하고 조리 도구를 청결하게 유지하는 것으로 예방할 수 있다.
2. 역사
살모넬라균은 1880년 카를 요제프 에베르트가 장티푸스 환자의 파이어판과 비장을 관찰하면서 처음 기록되었다.[128] 4년 후 게오르크 가프키는 살모넬라균 배양에 성공한다.[129] 1885년 시어벌드 스미스는 살모넬라 엔테리카(이전 이름 콜레라수이스)를 발견했는데,[130] 당시 스미스는 미국 농무부 수의학부에서 다니엘 엘머 살몬의 지도 아래 연구를 수행하고 있었다. 처음에는 이 균이 돼지콜레라의 병원균으로 여겨져 돼지콜레라바실루스(Hog-cholerabacillus)라고 명명되었다. 1900년 조셉 레온 리니에르가 살몬 연구팀이 발견한 박테리아를 살몬의 업적을 기려 살모넬라(''Salmonella'')로 부를 것을 제안했고, 이 용어가 지금까지 사용되고 있다.[131]
1930년대 후반, 오스트레일리아의 세균학자 낸시 애킨슨은 남호주 주 정부 병리학 및 세균학 연구소인 애들레이드(후에 의학 및 수의학 연구소)에 살모넬라 분류 연구실을 설립했다. 애킨슨은 1943년 분리된 살모넬라 애들레이드를 포함한 여러 새로운 살모넬라 균주를 묘사했고, 1957년 연구 결과를 발표했다.[15]
2. 1. 카를 요제프 에베르트의 발견 (1880년)
카를 요제프 에베르트는 1880년 장티푸스 환자의 파이어판과 비장에서 살모넬라균을 처음으로 관찰하였다.[128]2. 2. 게오르크 가프키의 순수배양 성공 (1884년)
1884년, 게오르크 가프키는 살모넬라균의 순수배양에 성공했다.[129]2. 3. 시어벌드 스미스의 살모넬라 엔테리카 발견 (1885년)
1885년, 시어벌드 스미스는 살모넬라 엔테리카(이전 이름 콜레라수이스)를 발견했다. 당시 스미스는 미국 농무부의 수의학부에서 수의병리학자 다니엘 엘머 살몬의 지도 하에 연구를 수행하고 있었다.[130] 처음에는 이 균이 돼지콜레라(hog colera)의 병원균으로 여겨져 돼지콜레라바실루스(Hog-cholerabacillus)라 명명되었다. 이후 살몬 연구팀이 발견한 박테리아들을 살몬의 업적을 기리고자 1900년에 살모넬라(''Salmonella'')라는 용어가 처음 사용되어 지금까지 그렇게 불리고 있다.[131]2. 4. 살모넬라 명명 (1900년)
1880년 카를 요제프 에베르트가 장티푸스 환자의 파이어판과 비장을 관찰함으로써 살모넬라균을 처음 기록하였다.[128] 1884년 게오르크 가프키는 살모넬라의 순수배양에 성공한다.[129] 1885년 시어벌드 스미스는 살모넬라 엔테리카(이전 이름 콜레라수이스)를 발견한다. 당시 스미스는 미국 농무부의 수의학부에서 수의병리학자 다니엘 엘머 살몬의 지도 하에 연구를 수행하고 있었다.[130] 처음에는 이 균이 돼지콜레라(hog colera)의 병원균이므로 돼지콜레라바실루스(Hog-cholerabacillus)라 명명하였다. 1900년 조셉 레온 리니에르가 살몬 연구팀이 발견한 박테리아들을 살몬의 업적을 기리고자 살모넬라(''Salmonella'')라는 용어를 제안했고, 이 용어가 지금까지 사용되고 있다.[131]2. 5. 낸시 애킨슨의 살모넬라 연구 (1930년대 후반 ~ 1957년)
1930년대 후반, 오스트레일리아의 세균학자 낸시 애킨슨은 당시 세계에서 단 3곳뿐이었던 살모넬라 분류 연구실을 남호주 주 정부의 병리학 및 세균학 연구소인 애들레이드(후에 의학 및 수의학 연구소)에 설립했다.[15] 이곳에서 애킨슨은 1943년에 분리된 살모넬라 애들레이드를 포함한 여러 새로운 살모넬라 균주를 묘사했다. 애킨슨은 1957년에 살모넬라에 대한 연구 결과를 발표했다.[15]3. 분류학
살모넬라속(Salmonella)은 장내세균과에 속하는 속으로, 그 하위 분류는 논란의 여지가 있지만 일반적으로 ''S. bongori''와 ''S. enterica'' 두 종으로 구성되며, ''S. enterica''는 다시 6개의 아종으로 나뉜다.[125][126]
살모넬라속의 분류는 세균 중에서도 가장 혼란스러운 것 중 하나로 여겨져, 분류와 학명 표기를 통일하기 위한 결정이 자주 이루어졌다. 초기에는 임상적 고려 사항에 따라 ''살모넬라 티피-무리움''(쥐 장티푸스) 등과 같이 각 "종"을 명명했으나, 숙주 특이성이 없는 경우가 많다는 것이 밝혀지면서, 새로운 균주는 분리된 위치에 따라 종 이름을 부여받았다.[41] 1987년에는 ''살모넬라''가 ''S. 엔테리카'' 하나의 종으로만 구성되어 있다는 주장이 제기되었고,[42] 1989년에는 ''S. 봉고리''라는 이름을 부활시켜야 한다는 제안도 있었다.[43] 2005년에는 ''S. 엔테리카'' 아래에 6개의 아종을 포함하는 현재의 명명법이 확립되었으나,[3][44][45][46] 전염병 전문가들은 새로운 명명법에 익숙하지 않아 기존 명명법을 사용하기도 한다.
지질다당류인 O 항원과 편모 H 항원 두 가지를 기준으로 2,500개 이상의 항원형으로 분류되며, 카우프만-화이트 분류 체계는 이러한 혈청학적 변종을 구분한다. 예를 들어, 장티푸스균은 ''Salmonella enterica'' subsp. ''enterica'' serotype Typhimurium과 같이 표현되지만, ''Salmonella'' Typhimurium으로 줄여 쓰기도 한다.[127]
고전적인 살모넬라속의 분류는 1926년 White가 제안하고 이후 카우프만(Kauffmann)이 확장한 '''카우프만-화이트 항원표'''에 따라 O항원과 H항원의 조합에 기반하여 이루어졌다. 그러나 이는 생화학적, 유전학적 분류와 불일치하여 2005년에는 ''S. enterica''와 ''S. bongori''를 1속 2종으로 하고, ''S. enterica'' 아래에 6개의 아종을 두는 분류법이 결정되었다.[105]
이러한 복잡한 분류 체계와 역사 때문에, 살모넬라 관련 연구나 문헌을 접할 때 주의가 필요하다.
3. 1. 살모넬라속의 종과 아종
살모넬라속(''Salmonella'')은 장내세균과에 속하는 속이다. 살모넬라속의 분류는 세균 중에서도 가장 혼란스러운 것 중 하나로 여겨지며, 학명 표기를 통일하기 위한 결정이 자주 이루어진다.[125][126]2005년 기준으로 살모넬라속은 생물학적 특징에 따라 ''S. enterica''와 ''S. bongori''의 두 종으로 분류되며, ''S. enterica''는 다시 6개의 아종으로 나뉜다.[8][9][105]
또한, 세포벽의 지질다당류인 O항원과 편모 단백질인 H항원의 조합에 따라 2,500종 이상의 혈청형으로 분류된다. 예를 들어, 장티푸스균의 공식 학명은 “''Salmonella enterica'' subspecies ''enterica'' serovar Typhi”이지만, ''S. enterica'' serovar Typhi''로 약칭하거나, 더 줄여서 ''S. Typhi''로 약칭하기도 한다.[105]
3. 2. 혈청형 분류
살모넬라속은 지질다당류인 O 항원과 편모 H 항원 두 가지로 판정되는 2,500개 이상의 항원형이 존재한다.[127] 이러한 항원형 분류는 카우프만-화이트 분류에 따른다. 예를 들어 장티푸스균의 경우 항원형까지 포함하면 ''Salmonella enterica'' subsp. ''enterica'' serotype Typhimurium이라는 긴 이름을 가지나 일반적으로 ''Salmonella'' Typhimurium으로 줄여 부른다.[127]균주를 구별하는 것은 역학 및 의료적으로 매우 중요하다. 균주는 펄스장겔전기영동법, 다좌위서열분석, 총유전체 서열분석 등의 분자생물학적 방법이나 항생제 특이성을 통해 구분한다.[127]
혈청형 분류는 특정 항원에 대한 항체와 세포를 혼합하여 수행하며, xMAP와 실시간 중합효소 연쇄 반응(real-time PCR)과 같이 DNA 서열을 기반으로 하는 새로운 방법도 개발되었다.[19][20]
2005년 기준으로, 살모넬라속(''Salmonella'')은 생물학적 특징에 따라 ''S''. ''enterica''la와 ''S''. ''bongori''la로 분류되며, ''S''. ''enterica''la는 6개의 아종으로 더 세분화된다. 또한, 혈청학적으로는 세포벽의 지질다당류(LPS)인 O항원과 편모 단백질인 H항원의 조합에 따라 2,500종 이상으로 분류된다.
고전적인 살모넬라속의 분류는 O항원과 H항원의 조합에 기반한 것으로, 1926년 White가 제안하고 이후 카우프만(Kauffmann)이 확장한 '''카우프만-화이트 항원표'''에 따라 이루어져 왔다.
3. 3. 학명 표기법의 변천과 혼란
장내세균과에 속하는 살모넬라속(Salmonella)의 분류는 여러 차례 개정되어 혼란을 야기하기도 했다. 초기에는 임상적 고려 사항에 따라 ''살모넬라 티피-무리움''(쥐 장티푸스), ''S. 콜레라에-수이스''(돼지 콜레라)와 같이 각 "종"을 명명했다.[41] 그러나 숙주 특이성이 없는 경우가 많다는 것이 밝혀지면서, 새로운 균주는 분리된 위치에 따라 종 이름을 부여받았다.[41]1987년, Le Minor와 Popoff는 분자생물학적 발견을 근거로 ''살모넬라''가 ''S. 엔테리카'' 단일 종으로 구성되며, 이전의 "종" 이름은 혈청형으로 변경되어야 한다고 주장했다.[42] 1989년, Reeves 등은 혈청형 V는 독립적인 종으로 유지되어야 하며, ''S. 봉고리''라는 이름을 부활시켜야 한다고 제안했다.[43]
2005년, 현재의 명명법은 ''S. 엔테리카'' 아래에 6개의 아종, 즉 ''엔테리카''(혈청형 I), ''살라메''(혈청형 II), ''아리조나에''(IIIa), ''디아리조나에''(IIIb), ''후테나에''(IV), ''인디카''(VI)를 포함하는 것으로 확립되었다.[3][44][45][46] 그러나 전염병 전문가들은 새로운 명명법에 익숙하지 않아 기존 명명법이 여전히 널리 사용되고 있다.
살모넬라속은 지질다당류인 O 항원과 편모 H 항원 두 가지를 기준으로 2,500개 이상의 항원형으로 분류된다.[125][126] 카우프만-화이트 분류 체계는 이러한 혈청학적 변종을 구분한다. 혈청형은 일반적으로 속, 종, 아종 그룹 다음에 분류되며, 대문자로 표기되지만 이탤릭체는 사용하지 않는다. 예를 들어, ''살모넬라 엔테리카'' 세로바르 티피무리움과 같다.
과거 살모넬라의 혈청형 명명은 카우프만-화이트 분류에 따라 이루어졌는데, 항원형이 다르면 다른 생물종으로 간주했다. 예를 들어, O9:Hd 항원형을 가진 살모넬라는 장티푸스균(구 일본명)이라는 별개의 종으로 취급되었다. 그러나 이는 생화학적, 유전학적 분류와 불일치하여 1985년에는 ''S. choleraesuis''를 1속 1종으로 하는 제안이 나왔고, 2002년에는 ''S. enterica''를 1속 1종으로 하는 것이 공식 학명으로 승인되었다.[105] 2005년에는 ''S. enterica''와 ''S. bongori''를 1속 2종으로 하고, ''S. enterica'' 아래에 6개의 아종을 두는 분류법이 확정되었다.[105]
이러한 분류법에 따르면, 장티푸스균, 파라티푸스균, 식중독성 살모넬라 등 대부분의 병원성 살모넬라는 ''S. enterica'' subsp. ''enterica''에 속한다. 이 아종 내에서 카우프만-화이트 분류에 따른 항원성 차이를 기반으로 한 '''혈청형'''(serovar) 분류가 이루어진다. 예를 들어, 장티푸스균의 공식 학명은 ''Salmonella enterica'' subspecies ''enterica'' serovar Typhi이지만, ''subspecies enterica''를 생략하고 ''S. enterica'' serovar Typhi로 줄여 쓸 수 있다. 공식적으로 인정되지는 않지만, ''S. Typhi''로 약칭하는 경우도 많다.
2005년에 결정된 살모넬라속 분류는 다음과 같다.[105]
한편, 2005년에 ''S. subterranea''가 보고되었으나, 2010년에 살모넬라속이 아닌 ''Escherichia hermannii''에 가깝다는 보고가 있었고, 2016년에는 비공식적으로 "Atlantibacter subterranea"라는 명칭이 제안되었다.[106]
살모넬라 균주를 구별하는 것은 역학 및 의료적으로 매우 중요하다.[127] 균주는 펄스장겔전기영동법, 다좌위서열분석, 총유전체 서열분석 등의 분자생물학적 방법이나 항생제 특이성을 통해 구분할 수 있다.[127]
4. 세균학적 특징
살모넬라속은 장내세균과에 속하는 세균으로, 유당을 분해하지 않고, 대부분 황화수소를 생성하며, 리신을 탈탄산하고, 구연산을 탄소원으로 이용할 수 있다. 이러한 생화학적 특징은 대장균, 적리균 등 다른 장내세균과 살모넬라균을 구별하는 데 중요하다. 살모넬라균은 말라카이트 그린, 담즙산, 셀렌산에 저항성이 있어, 이러한 물질을 첨가한 선택배지를 사용하여 살모넬라균을 우선적으로 검출할 수 있다. 열이나 산에는 약하지만 건조하거나 저온인 환경에서는 강하며, 냉동해도 죽지 않아 냉동식품에서도 살모넬라 식중독이 발생할 수 있다.
4. 1. 형태와 운동성
살모넬라속은 장내세균과에 속하는 세균이며, 크기는 약 0.5um × 2um의 막대 모양으로 주모성 편모를 가지고 운동성이 있다.
4. 2. 생화학적 특징
장내세균과(포도당을 혐기적으로 발효하는, 아포를 가지지 않는, 통성혐기성 그람음성 간균)에 속하는 세균이며, 크기는 약 0.5µm × 2µm의 막대 모양으로 주모성 편모를 가지고 운동성이 있다. 살모넬라속 세균은 유당을 분해하지 않고, 또한 대부분의 균주는 황화수소를 생성하며, 리신을 탈탄산하고, 구연산을 탄소원으로 이용할 수 있다. 이러한 생화학적 특징은 같은 장내세균과의 장관 병원성 세균(대장균, 적리균 등)과 감별하는 데 중요하다. 또한, 살모넬라균은 말라카이트 그린, 담즙산, 셀렌산에 저항성이 있으므로, 배지에 이러한 물질을 첨가한 것을 선택배지로 사용함으로써 살모넬라를 우선적으로 검출할 수 있다. 열이나 산에는 약하지만 건조나 저온에는 강하며, 냉동해도 불활화되지 않는다. 이러한 성질은 냉동식품에서도 살모넬라 식중독이 발생한다는 것과 관련이 있다.
4. 3. 배양 및 검출

대부분의 살모넬라 아종은 황화 수소를 생성하는데,[132] 이는 황산제일철을 포함한 배지로 쉽게 감지할 수 있다. 이렇게 분리한 대부분의 살모넬라는 운동성이 있는 단계와 운동성이 없는 두 단계로 나뉜다. 운동성이 없는 단계의 세균은 크라이기 시험관이나 디치판(ditch plate)를 통해 운동성이 있는 단계로 전환할 수 있다.[133] RVS broth 배지로 살모넬라균을 대량으로 번식시킬 수 있다.[134]
살모넬라 DNA에 다중 중합효소연쇄반응이나[135] 실시간 중합효소 연쇄 반응(RT-PCR)[136]을 실시하여 검출할 수도 있다.
4. 4. 생존 및 증식 조건
대부분의 살모넬라균은 숙주와 연관된 생활사를 가지지만, 오염된 화장실이나 수원에서도 수 주간 서식할 수 있으며, 이러한 장소는 숙주 간 전염을 촉진하는 세균 저장소의 기능을 한다.[142] 살모넬라균은 건조한 환경에서도 수년 이상 생존할 수 있는 것으로 알려져 있다.[143]
살모넬라균은 냉동으로는 죽일 수 없지만,[144][145] 자외선이나 고열에는 쉽게 파괴된다. 55°C에서 90분 가열하거나, 60°C에서 12분 가열하면 대부분 죽는다.[146] 조리 시에는 식품 내부가 75°C가 될 때까지 가열하는 것이 권장된다.[147][148]
살모넬라종은 사람의 소화관과 파충류 등의 동물에서 발견된다. 파충류나 양서류의 피부에서 발견되는 살모넬라균은 접촉을 통해 사람에게도 옮길 수 있다.[149] 감염된 사람이나 동물의 배설물에 의해 오염된 음식과 물 역시 세균을 옮길 수 있다.[150] 살모넬라균은 세포분열을 통해 40분마다 무성생식으로 분열한다.[131]
5. 병원성
살모넬라균은 세포내기생세균으로,[151] 상피세포, M세포, 대식세포, 수지상 세포 등 다양한 종류의 세포를 감염시킨다.[152] 조건혐기성 미생물이기도 하여 산소가 있는 환경에서는 산소를 사용해 ATP를 합성하고, 산소가 없는 환경에서는 발효를 통해 ATP를 합성한다.
대부분의 살모넬라 감염은 배설물에 오염된 식품 섭취로 발생한다. 항원형은 크게 장티푸스형과 비장티푸스형으로 나뉘는데, 장티푸스형은 사람에게만 감염되는 반면, 비장티푸스형은 인수공통감염병으로 더 흔하게 발생한다.
살모넬라균은 자연계에서 다양한 동물의 소화관 내에 존재하지만, 사람에게는 병원성을 나타낼 수 있다. 특히, 계란, 육류, 가금류, 생우유와 같은 동물성 식품을 통해 경구 섭취함으로써 감염되는 경우가 많다.[112]
살모넬라 감염증은 크게 장티푸스 또는 파라티푸스와 같은 중증 감염증과 식중독을 일으키는 경우로 나뉜다. 티푸스성 살모넬라는 사람에게만 감염되며 환자의 분변이나 오염된 환경을 통해 전파된다. 반면, 식중독성 살모넬라는 애완동물이나 가축에 상재하며 오염된 식품을 통해 식중독을 유발한다.
식품위생 분야에서는 '살모넬라속균'이라는 명칭이 공식적으로 사용된다. 일본의 가축전염병예방법에서는 ''S. Gallinarum pullorum'', ''S. Gallinarum Gallinarum''에 의한 가금 살모넬라증을 법정전염병으로, ''S. Abortusequi''에 의한 마 파라티푸스, ''S. Enteritidis'', ''S. Typhimurium'', ''S. Choleraesuis'', ''S. Dublin''에 의한 살모넬라증을 신고전염병으로 지정하고 있다.
5. 1. 세포내 기생
살모넬라 종은 세포내기생세균이다.[151] 상피세포, M세포, 대식세포, 수지상 세포 등 다양한 종류의 세포를 감염시킨다.[152] 조건혐기성 미생물이기도 하여 산소가 있는 환경에서는 산소를 사용해 ATP를 합성하고, 산소가 없는 환경에서는 발효를 통해 ATP를 합성한다.살모넬라는 숙주 세포 내외에서 모두 증식할 수 있는 세포내 기생체 (통성 세포내 기생성 세균)의 일종이다. 능동적으로 세포에 작용하여 엔도사이토시스를 활성화시켜 대식세포뿐만 아니라 일반적인 장관 상피 세포 등에도 침입할 수 있다.

살모넬라의 상피세포 세포내 침입에는 III형 분비 장치가 관여한다.[107] III형 분비 장치는 세균의 세포질 단백질을 세포 외부로 분비하기 위한 기구로, 세균의 편모와 유사한 구조체이다. 편모의 섬모에 해당하는 단백질을 숙주 세포에 찔러 넣어 이펙터 분자라고 불리는 단백질을 세포 내부에 직접 보낸다.[108]
살모넬라는 대장 상피세포 표면에 부착하여 III형 분비 장치를 찌르고 이펙터 분자를 보낸다. 이 때 보내지는 이펙터 분자(살모넬라 염색체 상의 SPI-1 영역 유전자에 코딩된 SopE, SipA 등의 단백질)는 세포 골격을 구성하는 액틴을 재구성하는 작용을 한다.[109][110] 이 작용으로 살모넬라 부착 주변에서 세포 형태가 변화(러플링)하여 위족과 같은 구조가 발달한다. 이 위족상 구조의 발달은 상피세포의 엔도사이토시스를 촉진하고, 이로 인해 살모넬라는 상피세포 내에 흡수된다(방아쇠 기전).[111]

살모넬라속 세균 중 티푸스균과 파라티푸스균은 대식세포에 감염되어 그 내부에서 증식하며, 이것이 장티푸스 발병에 관여한다. 살모넬라는 이물질로 인식되어 대식세포에 의해 식작용(포식작용)을 받는다.
대식세포는 식균에 특화된 세포로 강력한 살균 기전을 가지며, 탐식한 이물질을 파고솜(식포)이라는 소포에 넣고 세포 내 리소좀과 융합하여 파고리소좀을 형성, 리소좀 내부의 분해 효소와 활성 산소 등으로 분해한다. 비티푸스성 살모넬라를 포함한 많은 세균은 이 기전에 의해 살균된다.
반면 티푸스균은 파고솜 내부에서 소포막을 매개로 III형 분비 장치를 세포질 쪽으로 찔러 넣고, SPI-2 유전자 영역에 코딩된 티푸스균 특이적 효과 분자군을 주입한다. 이 효과 분자군은 파고솜과 리소좀의 융합을 저해하여 파고리소좀 형성을 억제, 티푸스균은 식균을 회피한다. 리소좀과 융합이 저해된 파고솜은 SCV(salmonella-containing vacuole)라는 특수 소포가 되고, 티푸스균은 그 내부에서 증식한다.
5. 2. 감염 경로
대부분의 살모넬라 감염은 동물이나 사람의 배설물로 오염된 음식을 섭취하여 발생한다. 살모넬라 혈청형은 크게 장티푸스형과 비장티푸스형으로 나눌 수 있다. 장티푸스형에는 살모넬라 티피(Salmonella Typhi)와 살모넬라 파라티피 A(Salmonella Paratyphi A)가 포함되며, 인체에 적응되어 다른 동물에서는 발견되지 않는다. 비장티푸스형은 더 흔하며, 일반적으로 자연 치유되는 위장 질환을 유발하고 다양한 동물을 감염시킬 수 있는 인수공통감염병이다.[57]살모넬라균은 주로 계란, 육류, 가금류, 생우유와 같은 동물성 식품을 통해 경구 섭취함으로써 감염된다.[112] 일부 살모넬라는 사람에게 장티푸스 또는 파라티푸스와 같은 중증 감염증이나 식중독을 일으킨다. 티푸스성 살모넬라는 사람에게만 감염되며, 환자의 분변을 통해 다른 사람에게 전파되거나, 분변에 오염된 토양이나 물을 통해 감염될 수 있다. 반면 식중독성 살모넬라균은 애완동물이나 가축의 장관에 상재균으로 존재하며, 오염된 식품 등이 식중독의 원인이 된다.
5. 3. 티푸스성 살모넬라
살모넬라 티피(''S. Typhi'')와 살모넬라 파라티피(''S. Paratyphi'')에 의한 장티푸스와 파라티푸스는 티푸스성 살모넬라 감염증이다.

장티푸스는 장티푸스균의 경구 감염으로 발병한다. 소화관에 도달한 장티푸스균은 장관 상피에 있는 파이어판에 근접한 M세포(융모가 발달하지 않고, 림프구와 대식세포에 이물질을 제시하고 전달하는 세포)에 흡수되고[115], 이를 매개로 대식세포에 의해 탐식된 후, 살균을 회피하고 그 세포 내에서 증식한다. 이 대식세포가 장간막 림프절에 감염을 확산시킴으로써, 장티푸스균은 림프절에서 증식하고, 혈액에 들어가 균혈증을 일으킨다. 임상 소견으로는, 2주 정도의 잠복기 후, 단계적으로 체온이 상승하여 40℃ 정도의 고열이 지속되고, 장미진이라고 불리는 담홍색의 발진이나 비장종대 등이 나타난다. 이어서, 담즙을 통해 장내에 다량으로 배균되고, 중증 환자의 경우에는 장벽이 괴사를 일으켜 장관 출혈이 발생한다. 그 후, 점차 해열하고 회복에 이른다.[57]
파라티푸스도 장티푸스와 유사한 증상을 보이지만, 장티푸스만큼 심각하지는 않다.[57]
치료는 뉴퀴놀론계 항균제 투여가 주가 되지만, 뉴퀴놀론제에 저감수성균이 있으므로, 그 경우에는 3세대 세펨계 항생물질이 사용된다.[116]
감염원은 사람의 분변이므로, 위생 상태가 좋은 지역에서는 발생이 적다. 아시아, 아프리카, 중남미 등에서 유행을 반복하고 있지만, 일본에서는 연간 100례 정도가 보고되고 있으며, 그 대부분이 해외에서 감염된 것이다.[116] 한국의 경우, 감염병의 예방 및 감염병 환자에 대한 의료에 관한 법률에 따라 3종 감염병으로 지정되어 있다.
살모넬라의 경우, 감염되어도 발병하지 않고 배균만 계속되는 경우가 있다. 또한 발병하여 증상이 치유된 후에도 장기간 배균이 계속되는 경우가 있다. 이를 살모넬라(장티푸스, 파라티푸스)의 '''잠복감염자'''(건강보균자)라고 한다. 식중독성 살모넬라균의 잠복감염자는 일반적으로 치료 대상이 아니지만, 식품 취급 종사자는 식중독 예방의 관점에서 배균이 멈출 때까지 항균제 복용을 지시받는다.
5. 4. 비티푸스성 살모넬라
비티푸스성 살모넬라균 감염은 일반적으로 식중독을 유발한다. 사람이 고농도의 박테리아를 포함하는 음식을 섭취할 때 발생한다. 영유아는 감염에 훨씬 더 취약하며, 소량의 박테리아를 섭취해도 쉽게 감염될 수 있다. 유아의 경우, 박테리아가 든 먼지를 흡입하여 감염될 수도 있다.살모넬라균은 소화관을 통해 들어가며, 건강한 성인에게 질병을 일으키려면 다량으로 섭취되어야 한다. 살아있는 살모넬라균(단순히 살모넬라균이 생성한 독소가 아님)이 위장관에 도달해야 감염이 시작될 수 있다. 일부 미생물은 위에서 죽지만, 살아남은 미생물은 소장으로 들어가 조직에서 증식한다. 위산은 섭취된 박테리아 대부분을 파괴하지만, 살모넬라균은 산성 환경에 대한 내성을 어느 정도 진화시켜 섭취된 박테리아의 일부가 생존할 수 있도록 한다.[61] 박테리아 집락은 식도에서 생성된 점액에 갇히기도 한다. 잠복기가 끝날 무렵, 주변 숙주 세포는 죽은 살모넬라균에서 방출된 내독소에 의해 중독된다. 내독소에 대한 국소 반응은 장염과 위장 장애이다.
약 2,000가지의 비티푸스성 살모넬라균 혈청형이 알려져 있으며, 이는 매년 미국에서 최대 140만 건의 질병을 일으킬 수 있다.[40] 심각한 질병의 위험이 있는 사람들은 영유아, 노인, 장기 이식 수혜자 및 면역 저하자를 포함한다.[40]
살모넬라의 상피세포 세포내 침입에는, III형 분비 장치(삼형분비장치)라고 불리는, 세균의 세포질 단백질을 세포 외부로 분비하기 위한 기구가 관여하고 있다.[107] III형 분비 장치는 세균의 편모와 유사한 구조체이며, 편모의 섬모에 상당하는 단백질을 숙주의 세포에 찌르고, 그 세포 내부에 직접 이펙터 분자라고 불리는 단백질을 보낸다.[108]
살모넬라는 대장 상피세포의 표면에 부착하고, 거기서 상피세포에 III형 분비 장치를 찌르고, 그 내부에 이펙터 분자를 보낸다. 이 때 보내지는 이펙터 분자(살모넬라 염색체 상의 SPI-1 영역의 유전자에 코딩된 SopE, SipA 등의 단백질)는, 세포 골격을 구성하는 액틴을 재구성하는 작용을 가지고 있으며,[109][110] 이 작용에 의해 살모넬라가 부착한 주변에서 세포의 형태가 변화(러플링이라고 불리는 구조 변화)하여, 부착한 세균 주변에서 위족과 같은 구조가 발달한다. 이 위족상 구조의 발달은 상피세포의 엔도사이토시스를 촉진하고, 이 엔도사이토시스에 의해 살모넬라는 상피세포 내에 흡수된다(방아쇠 기전).[111] 상피세포에 흡수된 살모넬라의 일부는 오토파지에 의해 분해되지만, 나머지는 그대로 엔도좀의 내부에서 증식한다.

살모넬라 식중독은 본균이 장관 상피세포에 감염된 결과로 발생하는 장관 내 액체 저류와 호중구 침윤에 의한 염증으로 일어난다고 생각된다. 전형적인 감염형 식중독이며, 주요 증상은 심한 복통, 구토, 심한 설사 등의 소화기 증상, 발열 등이다. 설사는 녹색 점액이 섞인 수양변이며, 때때로 김 조림과 같은 점혈변이 되는 경우도 있다. 또한, 다른 세균성 식중독에 비해 고열이 나는 경우가 많은 것이 특징이다. 보통 수일~1주일 정도면 회복되지만, 저항력이 없는 사람은 균혈증을 일으켜 중증화될 수 있다. 드물게 내독소에 의한 패혈증을 합병하여 사망하는 경우도 있다. 잠복기는 평균 12시간 정도라고 알려져 있지만, ''S''. Enteritidisla의 경우 3~4일이 되는 경우도 있다.[113] 일반적인 살모넬라속균에서는 발병하는 데 10만 개 이상의 균수가 필요하다고 알려져 있지만, ''S''. Enteritidisla는 100개 이하의 균수에서도 발병하는 경우가 있으며, 식품을 매개하지 않는 사람 간 감염도 보고되고 있다.[113]
대표적인 원인균으로는 ''S''. Enteritidisla, ''S''. Typhimuriumla, ''S''. Choleraesuisla, ''S''. Dublinla이 있다.
한국에서의 식중독 발생 건수의 1~3할이 살모넬라속균이 원인으로 여겨진다. 특히, 계란에서 유래한 과자에 의한 대규모 식중독이 눈에 띈다.
질병관리청의 “식품 중 식중독균 오염 실태 조사”에 따르면, 닭고기의 살모넬라 오염률은 50% 전후로 매우 높다.
애완동물로부터 감염되는 사례도 보고되고 있다.
치료는 대증요법과 퀴놀론계 항균제에 의한 살균이 된다. 그러나, 서구에서는 내성균을 유발하거나, 장내 세균총을 혼란시켜 치유를 늦춘다고 하여, 고령자나 소아를 제외하고는 항균제는 투여하지 않는 것이 주류가 되고 있다. 지사제는 배균을 저해하기 때문에 사용되지 않는다.
5. 5. 균혈증과 다장기 감염
면역 기능이 부족한 영유아나 노년층은 손상된 장관 점막을 통해 살모넬라균이 혈류로 침입할 수 있다.[62] 영유아에게는 수막염이 문제가 되며, 노년층에서는 대동맥에 형성된 죽종에 세균이 침착하는 경우가 있는데, 이는 대동맥류로 발전할 위험이 있다.[62] 그 외에도 여러 장기에 감염될 수 있지만, 혈액 배양 검사에서 혈류 감염이 확인되지 않는 한 특별히 걱정할 필요는 없다.[62]6. 항생제 내성
사람, 동물(특히 육계(브로일러), 칠면조) 등 동물 유래 육류 제품에서 분리된 살모넬라에서 일반적인 항균제에 대한 다제내성이 빈번하게 검출되고 있다. 2015년 유럽식품안전청(EFSA) 보고에 따르면, 살모넬라 분리주의 다제내성률은 다음과 같다.[117]
2018년~2019년에는 중증 감염증 치료에 사용되는 주요 항생물질 중 하나인 시프로플록사신에 대한 내성도 증가하고 있다. 2018년~2019년 시프로플록사신에 대한 감수성이 저하된 살모넬라균의 증가율은 다음과 같다.[118]
7. 생물테러 및 범죄 이용
살모넬라균은 생물테러나 범죄에 사용될 위험성이 지적되어 왔으며, 실제로 과거 몇몇 범죄에 이용된 사례가 있다. 이 때문에 각국에서는 살모넬라균 취급에 대한 제한을 마련하고 있다. 미국에서는 미국 질병통제예방센터(CDC)가 정한 병원체 범주 중, 범주 B(두 번째로 위험도가 높은 범주)의 "식품 안전을 위협하는 것"으로 살모넬라균을 지정하였다. 일본에서는 감염병예방법이 2007년에 개정되면서 티푸스균(S. Typhi|살모넬라 티피la) 및 파라티푸스 A균(S. Paratyphi A|살모넬라 파라티피 Ala)이 4종 병원체로 지정되어, 보관·운반·멸균 등의 취급 기준을 충족하는 시설에서 취급하도록 의무화하였다.[119]
일본에서는 장티푸스균이나 적리균을 이용한 바이오테러가 전쟁 전 2회, 전쟁 후 1회 발생하였다.
- 장티푸스 과자 살인 사건: 1936년부터 1937년에 걸쳐 발생하였다. 사이타마현의 한 의사가 아내에게 보험금을 걸고 장티푸스균에 오염된 과자로 살해하려 했으나 실패하였다. 이후 아내를 진찰한 의사가 사건을 알았다고 착각하여 그 의사 가족들에게도 장티푸스균에 오염된 과자와 음식을 먹였다.[120] 18명이 감염되었고, 그중 4명이 사망하였다.[121] 실행범인 의사는 1938년 우라와 지방법원에서 사형 판결을 받았다.[122]
- 장티푸스 만두 사건: 이혼한 상대와 그 가족에게 복수하기 위해 장티푸스균과 파라티푸스균에 오염된 만두를 보냈다. 12명이 감염되었고, 그중 1명이 사망하였다.
- 지바대학교 장티푸스 사건: 지바대학교 의학부 부속병원의 의국원이 담당 환자에게 장티푸스균과 적리균을 주입하거나 동료와 친척에게 세균에 감염된 음식을 먹였다. 64명이 감염되었으나 사망자는 없었다(억울한 누명일 가능성도 있음).[121]
8. 예방 방법
살모넬라 감염을 예방하기 위한 다양한 방법이 있다.
FDA, 미국 농무부, 식품안전검사국과 같은 기관에서는 공중 보건을 위해 살모넬라 감염 예방 표준과 검사를 시행하고 있다.[68] 질병통제예방센터는 날 음식 취급 및 보관 방법에 대한 정보를 제공하며,[69] 유럽식품안전청은 위험 관리 및 평가를 통해 예방 조치를 마련하고 있다.[69] 라틴 아메리카에서는 가금류의 살모넬라 경구 백신이 도입되어 사용되고 있다.[70]
최근 벨기에에서 생산된 초콜릿과 관련된 ''살모넬라'' 티피뮤리움 발생으로 인해 킨더 초콜릿 생산이 중단된 사례가 있다.[71][72]
8. 1. 식품 위생
살모넬라균 감염은 대부분 진단되지 않지만, 전 세계적으로 수많은 위장염 사례와 사망자를 발생시킨다.[63][64] 특히 어린이, 임산부, 노인, 면역 체계가 약한 사람들이 감염에 취약하다.[66]살모넬라 감염의 주요 원인은 오염된 육류, 채소, 콩나물, 가공식품 등이다.[67] 살모넬라균은 열에 약하므로, 식품을 충분히 가열하면 불활성화된다. 예를 들어, 전란이나 난황은 60°C에서 3.5분, 난백은 55°C에서 3.5분 가열하면 균이 제거된다. 식품 중에서는 68°C에서 3.5분이면 불활화된다.[124] 하지만 설탕이나 식염을 첨가하면 내열성이 증가하므로 주의해야 한다.[124]
살모넬라균은 10°C 이하, 46°C 이상에서는 증식이 지연되며, 5°C 이하 및 50°C 이상에서는 증식하지 않는다.[124] pH 10 이상 또는 4.75 이하에서도 증식하지 않지만, pH 4.0 마요네즈에서는 생존하고 pH 4.6에서 증식할 수 있다.[124] 또한, 수분 활성(aw) 0.95 이하에서는 증식하지 않는다.[124]
식품 제조소에서 사용되는 통상적인 소독제는 살모넬라균에 효과적이지만, 동결이나 건조 상태에서는 생존할 수 있다.[124] 따라서 식품 취급 시에는 위생 관리가 중요하다.
FDA, 미국 농무부, 식품안전검사국 등에서는 살모넬라 감염 예방을 위한 표준과 검사를 시행하고 있다.[68] 질병통제예방센터는 날 음식 취급 및 보관 방법에 대한 정보를 제공하며,[69] 유럽식품안전청은 위험 관리 및 평가를 통해 예방 조치를 마련하고 있다.[69]
8. 2. 백신 접종
티푸스균(''S''. typhi)에 대해서는 백신이 효과적이다.[124]
두 백신 모두 한국에서는 정식 승인되지 않았으므로, 개인 수입을 하는 의료기관에서만 접종할 수 있다.
남아시아 및 동남아시아 지역에서는 다제 내성 티푸스균(''S''. typhi)이 보고되고 있으므로, 백신 접종을 통한 예방이 중요하다.[124]
제산제(위산을 억제하는 약) 복용자나 위 절제술을 받은 사람은 장관 감염증의 위험이 높아지므로, 장티푸스 백신이나 콜레라·여행자 설사 백신 접종이 권장된다.[124]
참조
[1]
웹사이트
Salmonella
https://www.ncbi.nlm[...]
National Center for Biotechnology Information
2019-01-27
[2]
논문
Salmonella: clinical importance and evolution of nomenclature
2007-00-00
[3]
논문
Evaluation of the Complex Nomenclature of the Clinically and Veterinary Significant Pathogen Salmonella
2017-00-00
[4]
논문
Same species, different diseases: how and why typhoidal and non-typhoidal Salmonella enterica serovars differ
2014-00-00
[5]
논문
Salmonella enterica serovar Typhimurium skills to succeed in the host: virulence and regulation
2013-04-00
[6]
논문
Cellular aspects of immunity to intracellular Salmonella enterica
2011-03-00
[7]
서적
Sherris Medical Microbiology
McGraw Hill
[8]
논문
Salmonella nomenclature
2000-07-00
[9]
서적
Principles and practice of clinical bacteriology
John Wiley & Sons
2006-00-00
[10]
논문
Intracontinental spread of human invasive Salmonella Typhimurium pathovariants in sub-Saharan Africa
2012-11-00
[11]
논문
Die Organismen in den Organen bei Typhus abdominalis
1880-07-01
[12]
논문
Food, hygiene, and the laboratory. A short history of food poisoning in Britain, circa 1850-1950
1999-08-00
[13]
웹사이트
FDA/CFSAN—Food Safety A to Z Reference Guide—Salmonella
http://www.cfsan.fda[...]
2008-07-03
[14]
서적
Salmonella
https://books.google[...]
Chelsea House Publishers
2006-00-00
[15]
웹사이트
Atkinson, Nancy (1910–1999)
https://adb.anu.edu.[...]
[16]
웹사이트
Serotypes Profile of Salmonella Isolates from Meat and Poultry Products, January 1998 through December 2014
https://www.fsis.usd[...]
[17]
웹사이트
Steps in a Foodborne Outbreak Investigation
https://www.cdc.gov/[...]
2018-11-09
[18]
논문
Antibiotic Resistance Patterns and Serotypes of Salmonella spp. Isolated at Jeollanam-do in Korea
2017-06-00
[19]
논문
Comparison of xMAP Salmonella Serotyping Assay With Traditional Serotyping and Discordance Resolution by Whole Genome Sequencing
2020-09-07
[20]
논문
Real-Time PCR Assay for Differentiation of Typhoidal and Nontyphoidal Salmonella
2019-08-00
[21]
논문
The phs gene and hydrogen sulfide production by Salmonella typhimurium
1987-06-00
[22]
논문
UK Standards for Microbiology Investigations: Changing the Phase of Salmonella
https://www.gov.uk/g[...]
2015-01-08
[23]
서적
Handbook of Media for Clinical Microbiology
https://books.google[...]
CRC Press
2006-00-00
[24]
논문
Development of a multiplex PCR technique for detection and epidemiological typing of salmonella in human clinical samples
2004-04-00
[25]
논문
Automated 5' nuclease PCR assay for identification of Salmonella enterica
2000-09-00
[26]
논문
Modeling the growth of Salmonella in raw poultry stored under aerobic conditions
2008-12-00
[27]
논문
Modelling Salmonella concentration throughout the pork supply chain by considering growth and survival in fluctuating conditions of temperature, pH and a(w)
2011-03-00
[28]
논문
Modeling the growth of Salmonella in cut red round tomatoes as a function of temperature
2010-08-00
[29]
논문
Development and validation of a mathematical model for growth of pathogens in cut melons
2013-06-00
[30]
웹사이트
Development and validation of a mathematical model for growth of salmonella in cantaloupe
http://mss3.librarie[...]
[31]
논문
Role of nonhost environments in the lifestyles of Salmonella and Escherichia coli
2003-07-00
[32]
논문
Global Screening of Salmonella enterica Serovar Typhimurium Genes for Desiccation Survival
2017-09-08
[33]
논문
Pathogenicity of Salmonella gallinarum after metabolic injury by freezing
1970-01-00
[34]
논문
Salmonella survival on pecans as influenced by processing and storage conditions
1975-06-00
[35]
논문
Fate of Salmonella Inoculated into Beef for Cooking
1978-08-00
[36]
논문
Thermal inactivation of Salmonella in peanut butter
2009-08-01
[37]
웹사이트
Fight BAC! Basic Brochure
http://www.fightbac.[...]
2013-08-31
[38]
웹사이트
Internal Cooking Temperatures Chart
http://www.fsis.usda[...]
2012-05-03
[39]
웹사이트
Reptiles, Amphibians, and Salmonella
https://www.cdc.gov/[...]
U.S. Department of Health & Human Services
2013-11-25
[40]
논문
Foodborne diseases
2003-03-01
[41]
서적
Die Bakteriologie der Salmonella-Gruppe
Munksgaard
[42]
논문
Request for an Opinion: Designation of ''Salmonella enterica'' sp. nov., nom. rev., as the type and only species of the genus ''Salmonella''
[43]
논문
Clonal nature of Salmonella typhi and its genetic relatedness to other salmonellae as shown by multilocus enzyme electrophoresis, and proposal of Salmonella bongori comb. nov
1989-02-01
[44]
서적
The Enterobacteria
ASM Press
[45]
논문
The type species of the genus Salmonella Lignieres 1900 is Salmonella enterica (ex Kauffmann and Edwards 1952) Le Minor and Popoff 1987, with the type strain LT2T, and conservation of the epithet enterica in Salmonella enterica over all earlier epithets that may be applied to this species. Opinion 80
2005-01-01
[46]
논문
Nomenclature and taxonomy of the genus Salmonella
2005-01-01
[47]
서적
Salmonella: From Genome to Function
Caister Academic Press
[48]
논문
Multilocus sequence typing as a replacement for serotyping in Salmonella enterica
[49]
서적
Antigenic Formulae of the Salmonella Serovars
http://www.scacm.org[...]
WHO Collaborating Centre for Reference and Research on Salmonella
2007
[50]
논문
Phylogenetics of family Enterobacteriaceae and proposal to reclassify Escherichia hermannii and Salmonella subterranea as Atlantibacter hermannii and Atlantibacter subterranea gen. nov., comb. nov
2016-05-01
[51]
웹사이트
Species: Atlantibacter subterranea
https://lpsn.dsmz.de[...]
[52]
웹사이트
GTDB - Tree at g__Atlantibacter
https://gtdb.ecogeno[...]
[53]
웹사이트
Taxonomy browser (Atlantibacter)
https://www.ncbi.nlm[...]
[54]
웹사이트
GTDB - Tree at g__Salmonella
https://gtdb.ecogeno[...]
[55]
논문
Salmonellae interactions with host processes
2015-04-01
[56]
논문
Salmonella enterica serovars Typhimurium and Typhi as model organisms: revealing paradigm of host–pathogen interactions
2012-07-01
[57]
웹사이트
What is the difference between nontyphoidal salmonellae and S typhi or S paratyphi?
https://www.medscape[...]
[58]
논문
Salmonella enterica serovar Typhimurium skills to succeed in the host: virulence and regulation
2013-04-01
[59]
논문
Molecular modeling and active site analysis of SdiA homolog, a putative quorum sensor for Salmonella typhimurium pathogenecity reveals specific binding patterns of AHL transcriptional regulators
2012-10-01
[60]
논문
Salmonella plasmid virulence gene spvB enhances bacterial virulence by inhibiting autophagy in a zebrafish infection model
2016-02-01
[61]
논문
Role of acid tolerance response genes in Salmonella typhimurium virulence
1993-10-01
[62]
논문
Invasive non-typhoidal salmonella disease: an emerging and neglected tropical disease in Africa
2012-06-01
[63]
웹사이트
Salmonella (non-typhoidal)
https://www.who.int/[...]
[64]
논문
The global burden of nontyphoidal Salmonella gastroenteritis
2010-03-01
[65]
웹사이트
Salmonellosis - Annual Epidemiological Report 2016 [2014 data]
https://www.ecdc.eur[...]
2016-01-31
[66]
웹사이트
Get the Facts about Salmonella!
https://www.fda.gov/[...]
Center for Veterinary Medicine, FDA
2019-06-06
[67]
웹사이트
Prevention Salmonella CDC
https://www.cdc.gov/[...]
2019-03-06
[68]
웹사이트
Salmonella
https://www.fsis.usd[...]
[69]
웹사이트
Salmonella
https://www.efsa.eur[...]
[70]
웹사이트
Content not found
https://www.terrapin[...]
2022-03-03
[71]
논문
Salmonella Typhimurium outbreak linked to chocolate
2022-07-01
[72]
웹사이트
Kinder recall: ECDC urges further investigation at Belgian plant
https://www.euronews[...]
2022-04-15
[73]
간행물
§ 6 and § 7 of the German law on infectious disease prevention, Infektionsschutzgesetz
[74]
웹사이트
Anzahl der jährlich registrierten Salmonellose-Erkrankungen in Deutschland bis 2016
https://de.statista.[...]
Statista
[75]
웹사이트
Salmonella
https://www.cdc.gov/[...]
[76]
논문
The global burden of typhoid fever
2004-05-01
[77]
논문
Salmonella stress management and its relevance to behaviour during intestinal colonisation and infection
2005-11-01
[78]
논문
Salmonellae interplay with host cells
2008-01-01
[79]
논문
Inhibition of the PtdIns(5) kinase PIKfyve disrupts intracellular replication of Salmonella
2010-04-01
[80]
논문
The acetyltransferase activity of the bacterial toxin YopJ of Yersinia is activated by eukaryotic host cell inositol hexakisphosphate
2010-06-01
[81]
논문
A case of back pain caused by Salmonella spondylitis -A case report-
2010-12-01
[82]
뉴스
Bacterial protein mimics DNA to sabotage cells' defenses: Study reveals details of Salmonella infections
https://www.scienced[...]
[83]
논문
Salmonella thyroid abscess
2022-01-01
[84]
논문
Recombination-deficient mutants of Salmonella typhimurium are avirulent and sensitive to the oxidative burst of macrophages
1993-03-01
[85]
논문
Role of the RecBCD recombination pathway in Salmonella virulence
2002-01-01
[86]
논문
Comparative genome analysis of Salmonella Enteritidis PT4 and Salmonella Gallinarum 287/91 provides insights into evolutionary and host adaptation pathways
2008-10-01
[87]
논문
Genome sequencing reveals diversification of virulence factor content and possible host adaptation in distinct subpopulations of Salmonella enterica
2011-08-01
[88]
논문
A trans-acting leader RNA from a Salmonella virulence gene
2017-09-01
[89]
논문
Evolution of Salmonella enterica virulence via point mutations in the fimbrial adhesin
[90]
논문
Evolution of host adaptation in Salmonella enterica
1998-10-01
[91]
논문
Genome-Wide Comparative Functional Analyses Reveal Adaptations of Salmonella sv. Newport to a Plant Colonization Lifestyle
2018-01-01
[92]
논문
Typhoidal Salmonella: Distinctive virulence factors and pathogenesis
2018-09-01
[93]
논문
A mouse model for S. typhimurium-induced enterocolitis
2005-10-01
[94]
논문
Genetic exchange in Salmonella
1952-11-01
[95]
논문
A proposal for a uniform nomenclature in bacterial genetics
1966-07-01
[96]
논문
Methods for detecting carcinogens and mutagens with the Salmonella/mammalian-microsome mutagenicity test
1975-12-01
[97]
논문
A phage for the controlling of Salmonella in poultry and reducing biofilms
2022-06-01
[98]
논문
Emergence of human-adapted Salmonella enterica is linked to the Neolithization process
2020-03-01
[99]
논문
Pan-genome Analysis of Ancient and Modern Salmonella enterica Demonstrates Genomic Stability of the Invasive Para C Lineage for Millennia
2018-08-01
[100]
논문
Salmonella enterica genomes from victims of a major sixteenth-century epidemic in Mexico
2018-03-01
[101]
웹사이트
GTDB release 08-RS214
https://gtdb.ecogeno[...]
[102]
웹사이트
bac120_r214.sp_label
https://data.gtdb.ec[...]
[103]
웹사이트
Taxon History
https://gtdb.ecogeno[...]
[104]
논문
A complete domain-to-species taxonomy for Bacteria and Archaea.
https://www.research[...]
2020-09-01
[105]
간행물
Salmonella Surveillance: Annual Summary, 2005
http://www.cdc.gov/n[...]
US Department of Health and Human Services, CDC
2007-01-01
[106]
논문
Phylogenetics of family Enterobacteriaceae and proposal to reclassify Escherichia hermannii and Salmonella subterranea as Atlantibacter hermannii and Atlantibacter subterranea gen. nov., comb. nov.
2016-00-00
[107]
논문
Requirement for exported proteins in secretion through the invasion-associated type III system of Salmonella typhimurium
http://iai.asm.org/c[...]
1996-09-00
[108]
논문
Protein delivery into eukaryotic cells by type III secretion machines
2006-11-00
[109]
논문
Salmonella Virulence Effector SopE and Host GEF ARNO Cooperate to Recruit and Activate WAVE to Trigger Bacterial Invasion
2012-02-00
[110]
논문
Involvement of SipA in modulating actin dynamics during Salmonella invasion into cultured epithelial cells
2002-06-00
[111]
논문
S. typhimurium encodes an activator of Rho GTPases that induces membrane ruffling and nuclear responses in host cells
1998-00-00
[112]
웹사이트
サルモネラ症(チフス以外)(ファクトシート)
https://www.forth.go[...]
2022-05-09
[113]
웹사이트
サルモネラ感染症
http://wwwsoc.nii.ac[...]
岩手大学農学部獣医微生物学教室 弘前大学医学部細菌学教室
2014-09-00
[114]
기관
横浜市衛生研究所感染症・疫学情報課
[115]
논문
The role of M cells in Salmonella infection
2001-11-00
[116]
웹사이트
感染症のページ(青森県)
http://www.pref.aomo[...]
[117]
웹사이트
Salmonella and Campylobacter show significant levels of resistance to common antimicrobials in humans and animals
https://www.efsa.eur[...]
2022-05-09
[118]
웹사이트
US: Rising resistance among bacteria serotypes in poultry
https://www.poultryw[...]
2022-05-09
[119]
서적
病原微生物の取り扱いと安全
南山堂
2007-00-00
[120]
뉴스
チフス菌入り菓子で殺人の意思を検挙
東京日日新聞
1937-05-21
[121]
서적
バイオテロの包括的研究
朝日大学法制研究所
2003-00-00
[122]
뉴스
細菌魔に死刑の判決
東京朝日新聞
1938-07-05
[123]
뉴스
汚染馬肉荷揚げ拒否 横浜の港湾労働者が騒ぐ
朝日新聞
1970-09-17
[124]
논문
卵及び卵加工品におけるサルモネラエンテリティディスの汚染とその対策
1999-00-00
[125]
논문
Salmonella nomenclature
2000-07-00
[126]
서적
Principles and practice of clinical bacteriology
John Wiley & Sons
2006-00-00
[127]
논문
Intracontinental spread of human invasive Salmonella Typhimurium pathovariants in sub-Saharan Africa
2012-11-00
[128]
논문
Die Organismen in den Organen bei Typhus abdominalis
1880-07-01
[129]
논문
Food, hygiene, and the laboratory. A short history of food poisoning in Britain, circa 1850-1950
1999-08-00
[130]
웹사이트
FDA/CFSAN—Food Safety A to Z Reference Guide—Salmonella
http://www.cfsan.fda[...]
2009-02-14
[131]
서적
Salmonella
https://books.google[...]
Chelsea House Publishers
2015-07-31
[132]
논문
The phs gene and hydrogen sulfide production by Salmonella typhimurium
1987-06-00
[133]
논문
UK Standards for Microbiology Investigations: Changing the Phase of Salmonella
https://www.gov.uk/g[...]
2015-08-02
[134]
서적
Handbook of Media for Clinical Microbiology
https://books.google[...]
CRC Press
2006-00-00
[135]
논문
Development of a multiplex PCR technique for detection and epidemiological typing of salmonella in human clinical samples
2004-04-00
[136]
논문
Automated 5' nuclease PCR assay for identification of Salmonella enterica
http://jcm.asm.org/c[...]
2020-04-21
[137]
논문
Modelling the Growth of Salmonella in Raw Poultry Stored under Aerobic Conditions
http://www.ingentaco[...]
[138]
논문
Modelling Salmonella concentration throughout the pork supply chain by considering growth and survival in fluctuating conditions of temperature, pH and a(w)
2011-03-00
[139]
논문
Modelling the Growth of Salmonella in Cut Red Round Tomatoes as a Function of Temperature
http://www.ingentaco[...]
[140]
논문
Development and validation of a mathematical model for growth of pathogens in cut melons
2013-06-00
[141]
웹인용
Development and validation of a mathematical model for growth of salmonella in cantaloupe
https://archive.toda[...]
2020-04-26
[142]
저널
Role of nonhost environments in the lifestyles of Salmonella and Escherichia coli
http://digitalcommon[...]
2003-07-00
[143]
저널
Salmonella enterica Serovar Typhimurium Genes for Desiccation Survival
2017-09-08
[144]
저널
Pathogenicity of Salmonella gallinarum after metabolic injury by freezing
http://aem.asm.org/c[...]
1970-01-00
[145]
저널
Salmonella survival on pecans as influenced by processing and storage conditions
http://aem.asm.org/c[...]
2020-04-21
[146]
저널
Fate of Salmonella Inoculated into Beef for Cooking
1978-08-00
[147]
웹사이트
Fight BAC! Basic Brochure
http://www.fightbac.[...]
[148]
웹사이트
Internal Cooking Temperatures Chart
http://www.fsis.usda[...]
[149]
웹인용
Reptiles, Amphibians, and Salmonella
https://www.cdc.gov/[...]
U.S. Department of Health & Human Services
2013-08-03
[150]
저널
Foodborne Diseases: More efforts needed to meet the Healthy People 2010 objectives
[151]
저널
Cellular aspects of immunity to intracellular Salmonella enterica
2011-03-00
[152]
저널
Salmonellae interactions with host processes
2015-04-00
본 사이트는 AI가 위키백과와 뉴스 기사,정부 간행물,학술 논문등을 바탕으로 정보를 가공하여 제공하는 백과사전형 서비스입니다.
모든 문서는 AI에 의해 자동 생성되며, CC BY-SA 4.0 라이선스에 따라 이용할 수 있습니다.
하지만, 위키백과나 뉴스 기사 자체에 오류, 부정확한 정보, 또는 가짜 뉴스가 포함될 수 있으며, AI는 이러한 내용을 완벽하게 걸러내지 못할 수 있습니다.
따라서 제공되는 정보에 일부 오류나 편향이 있을 수 있으므로, 중요한 정보는 반드시 다른 출처를 통해 교차 검증하시기 바랍니다.
문의하기 : help@durumis.com
